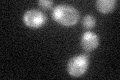
YDR443C
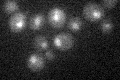
YDR443C

View description
Subunit of the RNA polymerase II mediator complex; associates with core polymerase subunits to form the RNA polymerase II holoenzyme; required for stable association of Srb10p-Srb11p kinase; essential for transcriptional regulation
Localization:
Intensity:
Fold change:
Significance:
-
C’ GFP library in SD

nucleus21.38 -
N' NOP1pr-GFP in SD

cytosol,nucleus57.4693 -
N' TEF2pr-mCherry in SD

cytosol0 -
N' NATIVEpr-GFP in SD

nucleus23.6509 -
N' TEF2pr-VC and Cyto-VN in SD

cytosol37.2283 -
C’ GFP library in SD+DTT

nucleus19.950.93No -
C’ GFP library in SD+H2O2
nucleus23.171.08No -
C’ GFP library in Starvation Media
nucleus19.090.89No -
C’ GFP library on the background of Pup2-DaMP

nucleus -
C’ GFP library on the background of CCT mutant

nucleus26.76731.25119No
